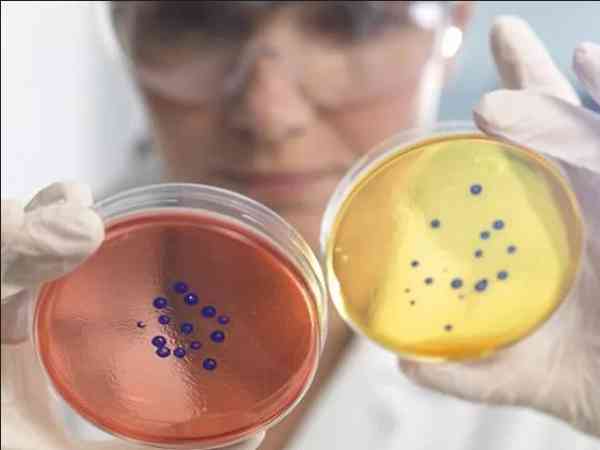

网传北医三院可以免费做第四代试管是真的吗?
我国国内暂时不能做第四代试管婴儿,因为第四代试管技术就是通过在老化卵子和年轻卵子之间做卵核置换,形成新的卵子再进行移植,这里面就会涉及到第三方女性,就会存在伦理问题,所以在国内是禁止的。全球首例第四代试管婴儿出生于乌克兰纳迪亚生殖医学诊所,乌克兰是第四代试管的发源地。目前而言,乌克兰这个国家很有可能支持这项技术,但是在国内肯定是禁止的。第四代试管婴儿技术涉及胞浆置换、线粒体移植等,在医学上称为线粒...

2023美国放出了哪些关于第四代试管技术的最新消息?
根据国际组织透露的第四代试管技术最新消息来看,目前第四代试管婴儿技术研究方向有两个,分别是卵浆质置换技术(GVT)、卵子干细胞技术(EggPCSM)。而卵浆质置换技术因为会涉及第三人,存在伦理问题,目前是被叫停的状态,而卵浆质置换技术是现在主流研究方向,通过获取女性自身的卵巢干细胞,提取出线粒体,然后注射到女性自身的卵细胞中,以提高卵细胞的质量。第四代试管婴儿的现有两个研究方向,其中卵浆质置换技术...

美国最新消息曝出四代试管婴儿有哪些优缺点?
美国第四代试管婴儿的优点主要就是其可以最大程度提高高龄女性的妊娠可能性,第四代试管婴儿的适应人群包括卵子质量不佳,身体情况不好的女性。但其也存在缺点,因为第四代试管婴儿是将健康女性与不孕女性的胞浆置换,所以孩子出生后就存在一父两母的情况,这会涉及到伦理问题,后期存在各种各种的争端。第四代试管婴儿就是卵胞浆置换技术(GVT,GerminalVesicleTransfer),目前主要应用于研究卵母细胞...

第四代试管婴儿主要解决了卵子老化的问题吗?
第四代试管婴儿技术主要解决了卵子老化以及携带有线粒体致病基因的问题,该技术涉及胞浆置换、线粒体移植等,是指用第三方的线粒体来替代卵母细胞中的线粒体,以及把老化卵子的卵核置换到年轻卵子的细胞质里面来合成新的卵子,然后与精子结合形成胚胎后,植入母体内。第四代试管婴儿技术简称GVT,也称为卵泡胞浆置换技术或胚胞转移技术。该技术通过将高龄女性卵子中的细胞核取出,放置于年轻女性卵子的细胞质中进行结合,从而形...

2023国内有第四代试管婴儿正规医院吗?哪家成功率比较高?
国内还没有可以开展第四代试管婴儿技术的医院,国内做试管比较好的医院一般都只开展了第一代、第二代、第三代试管婴儿技术。第四代试管婴儿技术在临床运用上还有不确定的因素,国内国外都没有将这项技术运用于临床上。因此想要在国内做试管的患者只能选择一代、二代、三代试管婴儿技术,这几项技术在国内试管婴儿医院中发展得也是很不多的,很多家医院的试管技术都都到了人们的广泛认可。国内做试管比较好的医院都没有开展第四代试...

2023泰国第四代试管婴儿单周期费用多少?
泰国目前并没有医院开展第四代试管技术,所以第四代试管婴儿费用48万是假的。目前泰国只有开展一代、二代、三代试管婴儿技术,其费用一般在8-15万元左右,即使是做供精供卵试管婴儿、三方助孕费用也达不到48万。全球范围内,只有美国有做过第四代试管婴儿,但后面也被叫停,现在四代试管婴儿技术还在研究中,具体多久才能临床应用还未知。泰国现在还没有四代试管婴儿吧!有也是国内那种中介想要吸引顾客的宣传词罢了,去了...
2023北京和上海有做四代试管的正规医院吗?
无论是北京还是上海,都说没有能做四代试管技术的,四代试管技术在我国是被禁止了的,当然在网上看到的哪儿能做四代试管的都是假的,包括国外能做四代试管的也是没有,四代试管技术在很早之前提出来的时候就起到了很多争议,因为四代试管技术是夫妻外加一个捐献卵子的女性来做试管。从第四代试管婴儿的技术手段中,我们可以看出,有第三方女性的存在。这和我国现行法律背道而驰,首先国家就不允许此项技术使用,其次,因为使用第四...

2023四代试管婴儿单周期费用多少?
四代试管费用应该会比第三代试管贵很多,但是由于第四代试管婴儿在全球范围内基本上没有开展,并没有临床数据,所以费用具体情况也是不明确的。第四代试管婴儿涉及胞浆置换、线粒体移植等,目前主要是针对某些线粒体遗传病的患者。由于存在伦理问题,目前在大多数国家(包括中国)都不允许开展。所以说,这个费用也就无法知晓。其实目前第一代、第二代、第三代试管已经能够满足很大部分的患者了,加上第四代试管技术在国内又是禁止...

2024俄罗斯三代试管婴儿成功率创新高,普遍达60%以上
俄罗斯联盟试管婴儿医院是全球最严格的医院之一,从官方数据来看,目前第四代试管婴儿技术研发上的突破,能够够将成功率提高到80%左右。即使是第三代试管婴儿,其成功率也达到了60%左右,而国内是30%~40%左右,成功率较高的原因是因为俄罗斯对于医院卫生标准相当的严格,大大提高了实验室囊胚培育成功的概率。试管婴儿成功的关键主要还是患者本身,如果说医生技术和囊胚培养室占40%,那么患者本身占60%因素,以...

美国ccrm助孕机构评价参考,附2024试管婴儿成功率及费用
CCRM科罗拉多辅助生殖医学中心在美国乃至全球都享有一定的知名度,是其中之一。该机构开展了除四代以外的所有辅助生殖技术,成功率较高。据一些患者评价,该机构环境整洁,医生专业,治疗效果可靠。目前,CCRM机构提供的三代试管技术成功率约为70%,收费标准为20-30万元。尽管价格较高,但该机构的治疗结果值得信赖。美国ccrm机构试管婴儿的口碑CCRM科罗拉多辅助生殖医学中心与HRC、南加州等试管婴儿机...

看了又看